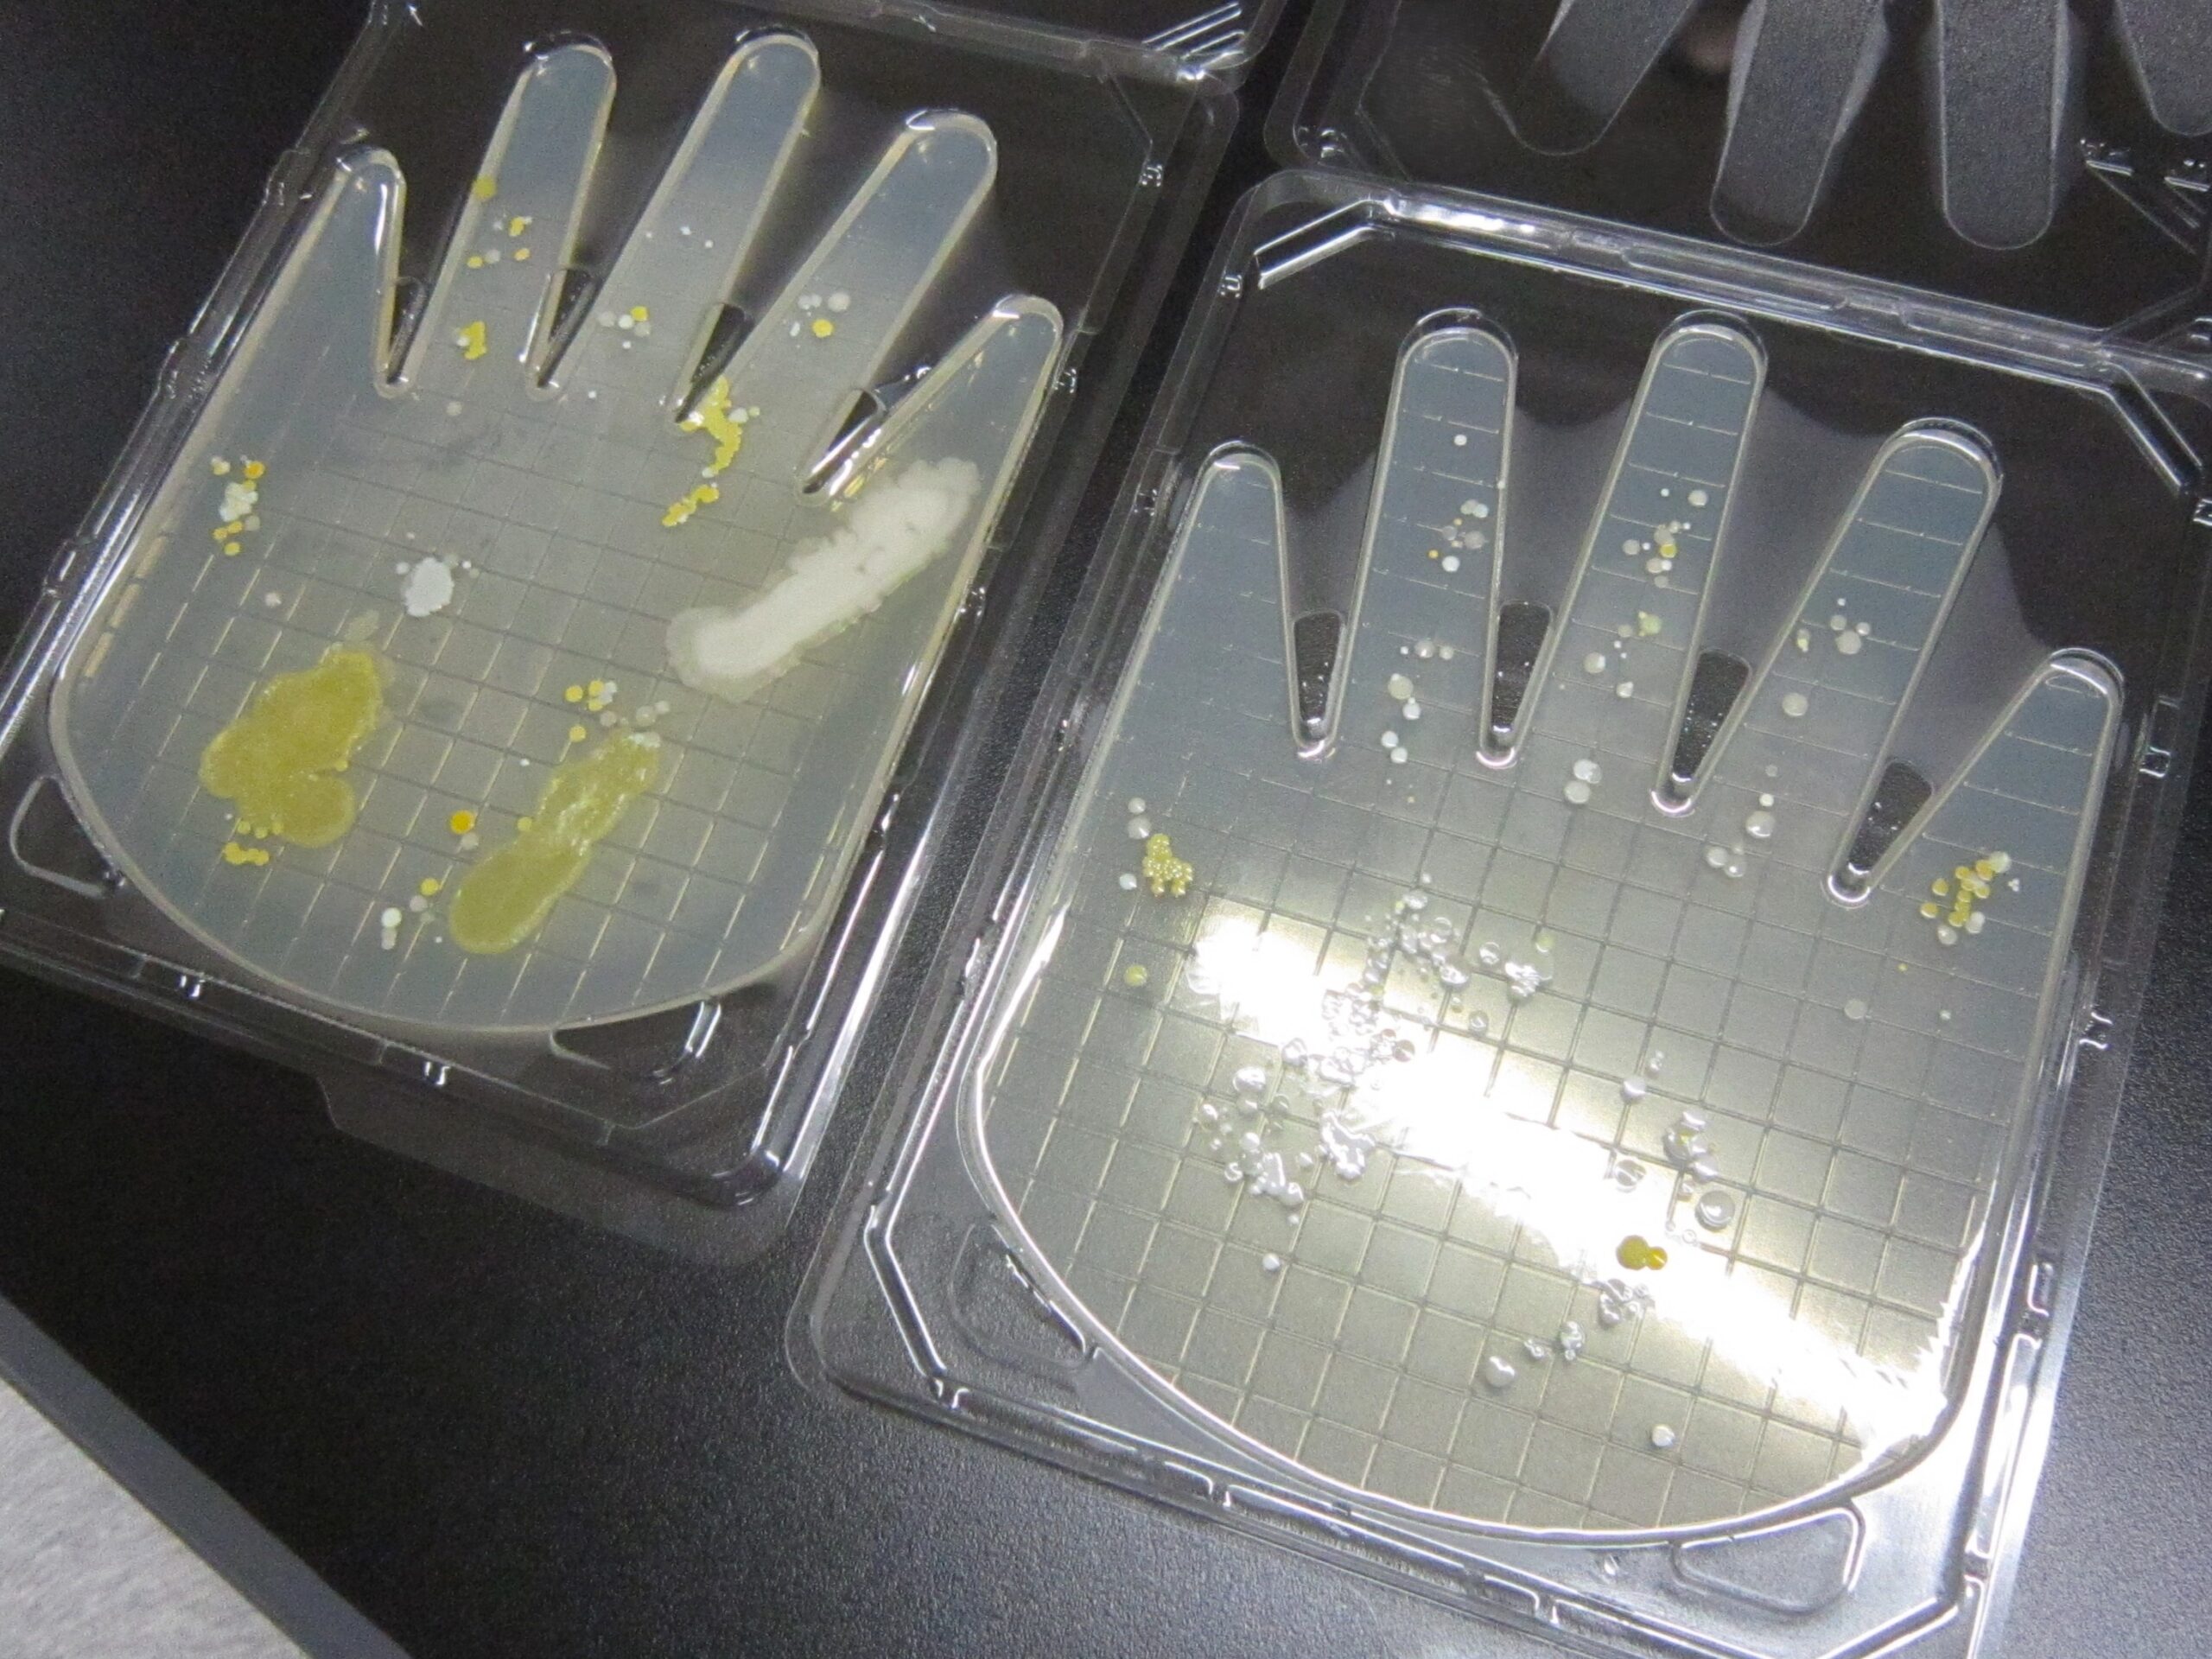
「培養の準備」

ニュース・プレスリリース
管理栄養士をめざす学生たちの実験授業紹介!「食品衛生学実験」
2025.10.17
その他
- 健康栄養学部

健康栄養学部2年生が行う「食品衛生学実験」をご紹介します。
今回の授業では、「手指の細菌検査」を行い、手洗いの効果や衛生管理の重要性について理解を深めました。
学生たちは、ハンドシャーレ(菌が育つゼリー状の栄養分が入った容器)に手指を押し当て、培養(一定の温度と時間で菌を育てる作業)を行います。目に見えなかった菌が時間の経過とともに育ち、成長して広がる様子を観察することができました。手洗い前後の比較を通して、日常の衛生習慣が食品の安全に与える影響の大きさを実際に体験しながら学ぶことができました。観察後は、「目に見えない菌の存在を認識できた」「手洗いの大切さを改めて意識するようになった」といった声が寄せられました。
食品衛生の知識と実践力は、管理栄養士として人々の健康を支えるために欠かせません。日々の生活や将来の仕事に活かせる力を身につけながら、学生たちは管理栄養士をめざして着実に成長を続けています。
なお、11月1日(土)には、大阪大手前キャンパスで「大手前フェスタ」が開催されます。衛生管理を学んだ健康栄養学部の学生も模擬店を出店し、授業での学びを活かした取り組みを披露します。ステージイベントなど楽しいプログラムも多数予定されていますので、ぜひお気軽にお立ち寄りください。
(配信元:食品栄養研究室)
